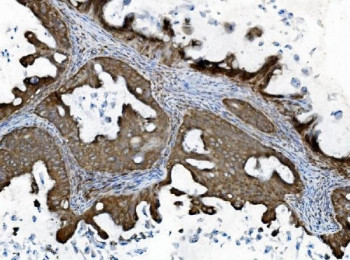
Anti-INPPL1 / SHIP2, clone 8C13

Cookie preferences
This website uses cookies, which are necessary for the technical operation of the website and are always set. Other cookies, which increase the comfort when using this website, are used for direct advertising or to facilitate interaction with other websites and social networks, are only set with your consent.
Configuration
Technically required
These cookies are necessary for the basic functions of the shop.
"Allow all cookies" cookie
"Decline all cookies" cookie
CSRF token
Cookie preferences
Currency change
Customer-specific caching
FACT-Finder tracking
Individual prices
Selected shop
Session
Comfort functions
These cookies are used to make the shopping experience even more appealing, for example for the recognition of the visitor.
Note
Show the facebook fanpage in the right blod sidebar
Statistics & Tracking
Affiliate program
Conversion and usertracking via Google Tag Manager
Track device being used
| Item number | Size | Datasheet | Manual | SDS | Delivery time | Quantity | Price |
|---|---|---|---|---|---|---|---|
| NSJ-RQ6359 | 100 µg | - | - |
3 - 10 business days* |
790.00€
|
If you have any questions, please use our Contact Form.
You can also order by e-mail: info@biomol.com
Larger quantity required? Request bulk
You can also order by e-mail: info@biomol.com
Larger quantity required? Request bulk
0.5mg/ml if reconstituted with 0.2ml sterile DI water. SH2-domain containing... more
Product information "Anti-INPPL1 / SHIP2, clone 8C13"
0.5mg/ml if reconstituted with 0.2ml sterile DI water. SH2-domain containing Phosphatidylinositol-3,4,5-trisphosphate 5-phosphatase 2 is an enzyme that in humans is encoded by the INPPL1 gene. The protein encoded by this gene is an SH2-containing 5'-inositol phosphatase that is involved in the regulation of insulin function. The encoded protein also plays a role in the regulation of epidermal growth factor receptor turnover and actin remodelling. Additionally, this gene supports metastatic growth in breast cancer and is a valuable biomarker for breast cancer. Protein function: Phosphatidylinositol (PtdIns) phosphatase that specifically hydrolyzes the 5-phosphate of phosphatidylinositol-3,4,5-trisphosphate (PtdIns(3,4,5)P3) to produce PtdIns(3,4)P2, thereby negatively regulating the PI3K (phosphoinositide 3-kinase) pathways. Plays a central role in regulation of PI3K-dependent insulin signaling, although the precise molecular mechanisms and signaling pathways remain unclear. While overexpression reduces both insulin-stimulated MAP kinase and Akt activation, its absence does not affect insulin signaling or GLUT4 trafficking. Confers resistance to dietary obesity. May act by regulating AKT2, but not AKT1, phosphorylation at the plasma membrane. Part of a signaling pathway that regulates actin cytoskeleton remodeling. Required for the maintenance and dynamic remodeling of actin structures as well as in endocytosis, having a major impact on ligand-induced EGFR internalization and degradation. Participates in regulation of cortical and submembraneous actin by hydrolyzing PtdIns(3,4,5)P3 thereby regulating membrane ruffling (PubMed:21624956). Regulates cell adhesion and cell spreading. Required for HGF-mediated lamellipodium formation, cell scattering and spreading. Acts as a negative regulator of EPHA2 receptor endocytosis by inhibiting via PI3K-dependent Rac1 activation. Acts as a regulator of neuritogenesis by regulating PtdIns(3,4,5)P3 level and is required to form an initial protrusive pattern, and later, maintain proper neurite outgrowth. Acts as a negative regulator of the FC-gamma-RIIA receptor (FCGR2A). Mediates signaling from the FC-gamma-RIIB receptor (FCGR2B), playing a central role in terminating signal transduction from activating immune/hematopoietic cell receptor systems. Involved in EGF signaling pathway. Upon stimulation by EGF, it is recruited by EGFR and dephosphorylates PtdIns(3,4,5)P3. Plays a negative role in regulating the PI3K-PKB pathway, possibly by inhibiting PKB activity. Down- regulates Fc-gamma-R-mediated phagocytosis in macrophages independently of INPP5D/SHIP1. In macrophages, down-regulates NF-kappa-B-dependent gene transcription by regulating macrophage colony-stimulating factor (M-CSF)-induced signaling. May also hydrolyze PtdIns(1,3,4,5)P4, and could thus affect the levels of the higher inositol polyphosphates like InsP6. Involved in endochondral ossification. [The UniProt Consortium]
| Keywords: | Anti-SHIP2, Anti-SHIP-2, Anti-INPPL1, Anti-INPPL-1, Anti-Protein 51C, Anti-SH2 domain-containing inositol phosphatase 2, Anti-SH2 domain-containing inositol 5'-phosphatase 2, Anti-Inositol polyphosphate phosphatase-like protein 1, INPPL1 Antibody / SHIP2 |
| Supplier: | NSJ Bioreagents |
| Supplier-Nr: | RQ6359 |
Properties
| Application: | WB, IHC (paraffin), IF, FC |
| Antibody Type: | Monoclonal |
| Clone: | 8C13 |
| Conjugate: | No |
| Host: | Mouse |
| Species reactivity: | human, mouse, rat |
| Immunogen: | Recombinant human protein (amino acids R1172-K1258) |
| Format: | Purified |
Database Information
| KEGG ID : | K15909 | Matching products |
| UniProt ID : | O15357 | Matching products |
| Gene ID : | GeneID 3636 | Matching products |
Handling & Safety
| Storage: | +4°C |
| Shipping: | +4°C (International: +4°C) |
Caution
Our products are for laboratory research use only: Not for administration to humans!
Our products are for laboratory research use only: Not for administration to humans!
Information about the product reference will follow.
more
You will get a certificate here
Viewed